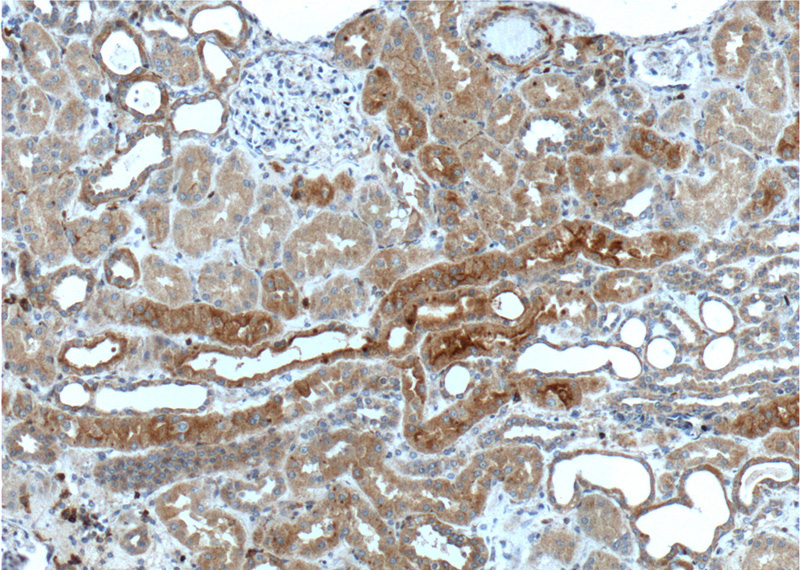
Immunohistochemistry of paraffin-embedded human kidney tissue slide using Catalog No:113308(NOTCH1 Antibody) at dilution of 1:200 (under 10x lens).

-
Product Name
NOTCH1 antibody
- Documents
-
Description
NOTCH1 Rabbit Polyclonal antibody. Positive IP detected in HepG2 cells. Positive WB detected in HepG2 cells, HeLa cells. Positive IHC detected in human kidney tissue, human lung tissue, human ovary tumor tissue, human spleen tissue, mouse brain tissue, mouse liver tissue. Observed molecular weight by Western-blot: 270-300 kDa
-
Tested applications
ELISA, WB, IP, IHC
-
Species reactivity
Human,Mouse,Rat,Zebrafish; other species not tested.
-
Alternative names
hN1 antibody; Notch 1 antibody; NOTCH1 antibody; TAN1 antibody
-
Isotype
Rabbit IgG
-
Preparation
This antibody was obtained by immunization of Peptide (Accession Number: NM_017617). Purification method: Antigen affinity purified.
-
Clonality
Polyclonal
-
Formulation
PBS with 0.02% sodium azide and 50% glycerol pH 7.3.
-
Storage instructions
Store at -20℃. DO NOT ALIQUOT
-
Applications
Recommended Dilution:
WB: 1:200-1:2000
IP: 1:200-1:1000
IHC: 1:50-1:500
-
Validations

HepG2 cells were subjected to SDS PAGE followed by western blot with Catalog No:113308(NOTCH1 antibody) at dilution of 1:500

IP Result of anti-NOTCH1 (IP:Catalog No:113308, 5ug; Detection:Catalog No:113308 1:200) with HepG2 cells lysate 2400ug.
Immunohistochemistry of paraffin-embedded human kidney tissue slide using Catalog No:113308(NOTCH1 Antibody) at dilution of 1:200 (under 10x lens).

Immunohistochemistry of paraffin-embedded human kidney tissue slide using Catalog No:113308(NOTCH1 Antibody) at dilution of 1:200 (under 40x lens).
-
Background
NOTCH1, also named as TAN1, belongs to the NOTCH family. NOTCH1 functions as a receptor for membrane-bound ligands Jagged1, Jagged2 and Delta1 to regulate cell-fate determination. Upon ligand activation through the released notch intracellular domain (NICD) it forms a transcriptional activator complex with RBP-J kappa and activates genes of the enhancer of split locus. NOTCH1 affects the implementation of differentiation, proliferation and apoptotic programs. It may be important for normal lymphocyte function. In altered form, may contribute to transformation or progression in some T-cell neoplasms. NOTCH1 is involved in the maturation of both CD4+ and CD8+ cells in the thymus. May be important for follicular differentiation and possibly cell fate selection within the follicle. During cerebellar development, may function as a receptor for neuronal DNER and may be involved in the differentiation of Bergmann glia. Defects in NOTCH1 are a cause of bicuspid aortic valve (BAV). Notch is synthesized in the endoplasmic reticulum as an inactive form which is proteolytically cleaved by a furin-like convertase (S1 cleavage) in the trans-golgi network before it reaches the plasma membrane to yield an active, ligand-accessible form. Cleavage results in a C-terminal fragment N(TM) and a N-terminal fragment N(EC). Following ligand binding, it is cleaved (S2 cleavage) by TNF-alpha converting enzyme (TACE) to yield a membrane-associated intermediate fragment called Notch extracellular truncation (NEXT). This fragment is then cleaved by presenilin-dependent gamma-secretase (S3 cleavage) to release the intracellular domain (NICD) from the membrane. The antibody is specific to NOTCH1. It can recognize the full length NOTCH1(270 kDa) and all the three cleaved NOTCH1 forms.
-
References
- Martin LJ, Katzenelson A, Koehler RC, Chang Q. The olfactory bulb in newborn piglet is a reservoir of neural stem and progenitor cells. PloS one. 8(11):e81105. 2013.
- Sun Q, Wang R, Wang Y, Luo J, Wang P, Cheng B. Notch1 is a potential therapeutic target for the treatment of human hepatitis B virus X protein-associated hepatocellular carcinoma. Oncology reports. 31(2):933-9. 2014.
- Annani-Akollor ME, Wang S, Fan J, Liu L, Padhiar AA, Zhang J. Downregulated protein O-fucosyl transferase 1 (Pofut1) expression exerts antiproliferative and antiadhesive effects on hepatocytes by inhibiting Notch signalling. Biomedicine & pharmacotherapy = Biomédecine & pharmacothérapie. 68(6):785-90. 2014.
Related Products / Services
Please note: All products are "FOR RESEARCH USE ONLY AND ARE NOT INTENDED FOR DIAGNOSTIC OR THERAPEUTIC USE"
